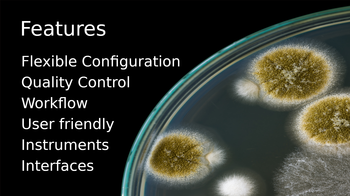
Card at Bika Lab Systems' website, www.bikalabs.com

Bika Lab Systems has a website again
Trying to be different
13 December 2021, Cape Town, Lemoene
Primary Bika LIMS project sponsor, Bika Lab Systems, has a website again, a cheerful attempt to not present sterile lab environments (only), and use sample origins and client imagery too
Front page carousel slides:
Front page cards:
![]() |
![]() |
![]() |
![]() |
![]() |
![]() |